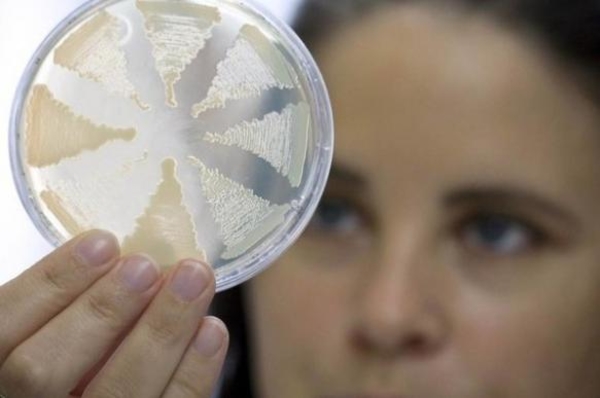
Что следует знать о ботулизме

Что следует знать о ботулизме

Читай также: Как оставаться энергичной и здоровой на карантине
С начала 2020 года в Украине зарегистрировано 13 случаев ботулизма, заболели 15 человек. Из них 14 взрослых и один ребенок в возрасте 9 лет.
Ботулизм - это тяжелое пищевое отравление, вызванное потреблением продуктов, содержащих ботулотоксины. Лучший способ защитить свое здоровье - воздерживаться от приема пищи, о качестве которой потребителю неизвестно.

Симптомы ботулизма:
- Нарушение зрения (двоение или туман в глазах, невнятность речи, тяжесть глотания, сухость во рту, мышечная слабость).
- У каждого второго больного, первыми проявлениями ботулизма могут быть кратковременные симптомы интоксикации: понос, рвота, может незначительно повыситься температура, болеть живот.
- Тяжелые формы заболевания характеризуются резким угнетением функции дыхательных мышц. При отсутствии адекватной терапии, смерть обычно наступает от дыхательной недостаточности на 2-3-й день болезни.
- У детей симптомы ботулизма могут проявляться в виде апатии, отказ от еды, длительного плача, а также мышечной слабости.
Инкубационный период может длиться от 2-3 часов до 10 дней.
При возникновении любого из этих симптомов нужно срочно обратиться за помощью к врачу.
В каких продуктах может быть?
- Неправильно приготовленные консервы (особенно домашние); мед!, колбасные изделия, соленая, копченая рыба.
- Мед может содержать споры ботулизма, которые прямо в кишечнике «дозревают» и начинают продуцировать токсин. Как результат - младенческий ботулизм.
Как предотвратить ботулизм:
- Никогда не употребляйте консервы из вздутых банок
- Не употребляйте консервированные продукты с неприятным запахом
- Если при открытии консервы жидкость вырывается под давлением – выбросьте в мусор!
- Никогда не пробуйте давать детям до 12 месяцев мед!!! (особенно для бабушек!)
- Мясо и рыбу разрешено консервировать только в свежем виде.
- Овощи и фрукты перед консервированием тщательно обмыть для удаления частиц почвы.
Если консервируете дома, соблюдайте правила безопасности:
- используйте только хорошо очищенные, свежие овощи и фрукты, без темных пятен
- при консервировании в домашних условиях, особенно мясных и рыбных продуктов, необходимо проводить тиндализацию (в течение двух суток прогревать консервы при температуре 100°С 5 минут для перехода спор в вегетативную форму), после чего простерилизовать консервы при температуре 100°С - не менее 40-60 минут с последующей герметичной упаковкой.
- Домашние консервы храните в темном прохладном месте
- Если во время хранения крышки на банках вздулись, – эти консервы употреблять в пищу запрещено
- В домашних условиях грибы можно заготавливать впрок только путем маринования или соления с добавлением достаточного количества кислоты и соли и обязательно в открытой для доступа воздуха таре.
Ранее мы писали, чем корь отличается от коронавируса.






